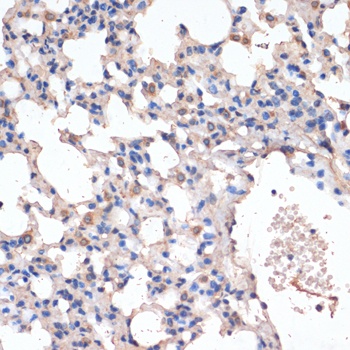
CD163 Antibody抗体,orb1255873,bi

相关产品推荐更多 >
万千商家帮你免费找货
0 人在求购买到急需产品
- 详细信息
- 技术资料
- 抗体名:
CD163 Antibody抗体
- 抗体英文名:
CD163 Antibody
- 靶点:
CD163
- 浓度:
batch dependent
- 应用范围:
IF, IHC, WB
- 适应物种:
Human, Mouse, Rat
- 保质期:
6-12个月
- 抗原来源:
详询
- 目录编号:
orb1255873
- 级别:
科研级
- 库存:
88
- 供应商:
biorbyt
- 标记物:
Unconjugated
- 克隆性:
Polyclonal
- 形态:
Liquid
- 亚型:
IgG
- 免疫原:
Recombinant fusion protein containing a sequence corresponding to amino acids 750-1050 of human CD163 (NP_004235.4).
- 规格:
100 ul
产品描述:CD163 Antibody
别名:CD163, CD163 antigen, Macrophage-associated antigen, M130, CD163 molecule, Hemoglobin scavenger receptor, MM130
免疫原:Recombinant fusion protein containing a sequence corresponding to amino acids 750-1050 of human CD163 (NP_004235.4).
分子量:Observed: 180kDa
应用注释:WB: 1:500 - 1:1000IHC: 1:50 - 1:200IF: 1:100 - 1:200
防腐剂:Liquid
纯化:Affinity 纯化
保存说明:Maintain refrigerated at 2-8°C for up to 2 weeks. For long term storage store at -20°C in small aliquots to prevent freeze-thaw cycles.
UniProt ID:Q86VB7
Note:For research use only.



别名:CD163, CD163 antigen, Macrophage-associated antigen, M130, CD163 molecule, Hemoglobin scavenger receptor, MM130
免疫原:Recombinant fusion protein containing a sequence corresponding to amino acids 750-1050 of human CD163 (NP_004235.4).
分子量:Observed: 180kDa
应用注释:WB: 1:500 - 1:1000IHC: 1:50 - 1:200IF: 1:100 - 1:200
防腐剂:Liquid
纯化:Affinity 纯化
保存说明:Maintain refrigerated at 2-8°C for up to 2 weeks. For long term storage store at -20°C in small aliquots to prevent freeze-thaw cycles.
UniProt ID:Q86VB7
Note:For research use only.

Western blot analysis of extracts of various cell lines, using CD163 Antibody (orb1255873) at 1:1000 dilution. Secondary antibody: HRP Goat Anti-Rabbit IgG (H+L) at 1:10000 dilution. Lysates/proteins: 25 ug per lane. Blocking buffer: 3% nonfat dry milk in TBST. Detection: ECL Basic Kit. Exposure time: 10s.
Immunohistochemistry of paraffin-embedded mouse lung using CD163 antibody (orb1255873) at dilution of 1:100 (40x lens).

Immunohistochemistry of paraffin-embedded Rat lung using CD163 antibody (orb1255873) at dilution of 1:100 (40x lens).
风险提示:丁香通仅作为第三方平台,为商家信息发布提供平台空间。用户咨询产品时请注意保护个人信息及财产安全,合理判断,谨慎选购商品,商家和用户对交易行为负责。对于医疗器械类产品,请先查证核实企业经营资质和医疗器械产品注册证情况。
技术资料暂无技术资料 索取技术资料
CD163 Antibody抗体,orb1255873,biorbyt
¥10400










